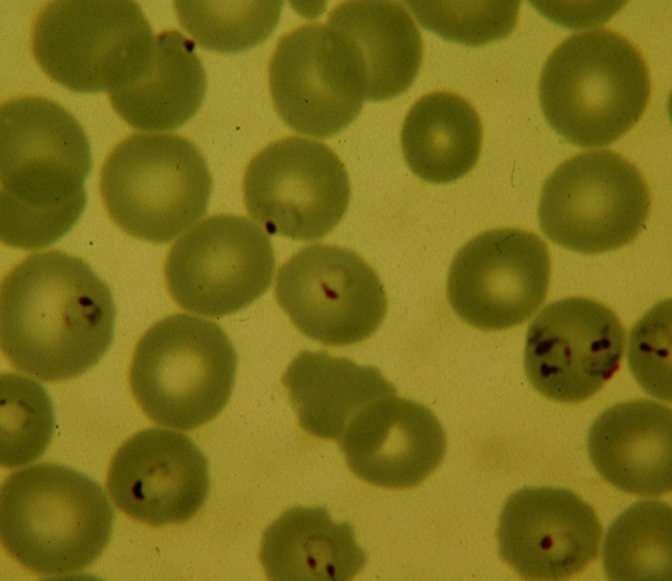
UK NEQAS Microbiology tweet media

Advancing gender equality drives stronger scientific outcomes. For #IWD2026 and #GiveToGain, we recognise how shared expertise, mentoring and collaboration enhance capability across @ukneqasmicro and the microbiology community.#WomenInScience

English